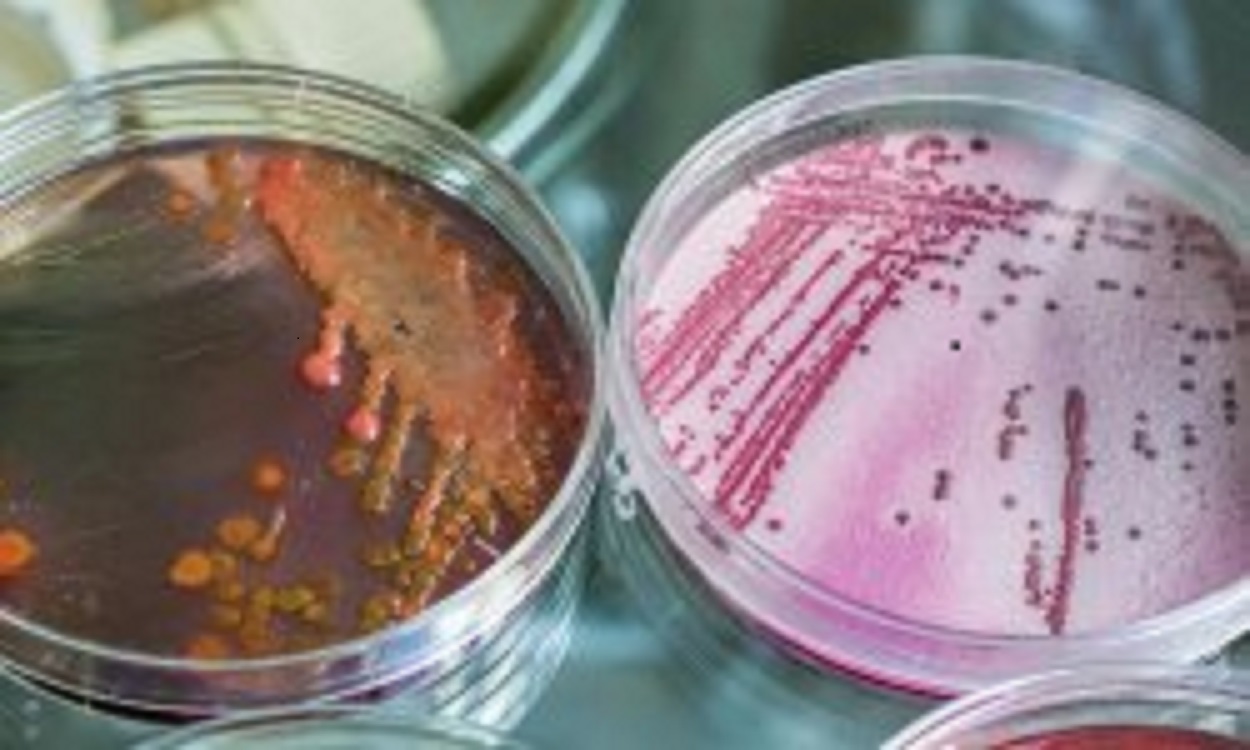

Dextrose technologies Bangalore offers a variety of Microbiological services, such as Testing and Analyzing products.
Ex : Antimicrobial activity, MIC, MBC etc.
We also deal with the dental pathogens both anaerobic and aerobic microorganisms.
Ex: E. faecalis, S. Mutans, P. Gingivalis, C. albicans, etc.
For More Details :
Log onto : http://www.dextrosetechs.com/
Mail : interface@dextrosetech.com
Contact : 9686928701




